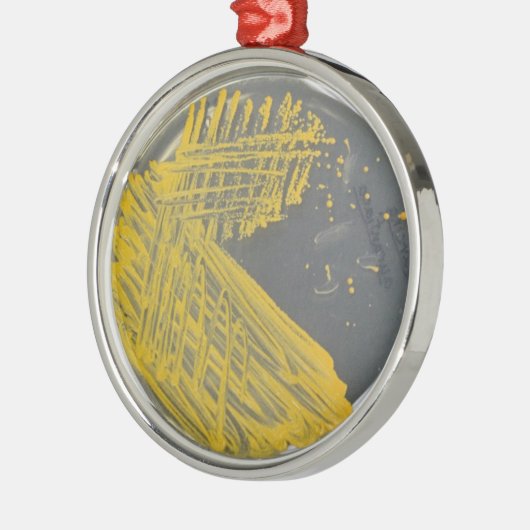
Isolation Streak of Bacteria Metalen Ornament (Links)

Over Ornamenten
Aangeboden door
Over dit ontwerp
Isolation Streak of Bacteria Metalen Ornament
Dit is een isolatiegebied van een gangbare milieubacterie Sarcina op een petrischaaltje.
Ontwerp van international designer
Klant beoordelingen
5.0 van 5 sterren beoordeling4 aantal beoordelingen
4 Reviews
Beoordelingen voor identieke producten
5 van 5 sterren beoordeling
Door Wiel C.17 december 2019 • Geverifieerde aankoop
Premium Rond Ornament
Zazzler recensent programma
Goede kwaliteit.
Mooie kleuren.
Precies zo als ik het mij voorgesteld had. Prachtig kado voor iemand die van zijn hond houd.
5 van 5 sterren beoordeling
Door E.3 december 2013 • Geverifieerde aankoop
Keramisch ovaal ornament
Zazzler recensent programma
Vlak voor kerst overleed onze liefste poes. Ik wilde een gedenkhanger maken zodat we haar
toch met kerst bij ons zouden voelen. En het werd prachtig. De foto is mooi duidelijk en je kon
een eigen tekst ingeven. Het is helemaal geworden wat ik ervan had gehoopt. Mooi stevig
materiaal en een gouden bindkoordje erbij. Helemaal af. Prachtig scherp en heldere kleuren
5 van 5 sterren beoordeling
Door E.26 december 2012 • Geverifieerde aankoop
Keramisch hart ornament
Zazzler recensent programma
Heb er even op moeten wachten maar had het voor de kerst binnen.
De gene waar het voor was was er heel erg blij mee
Dus vind ik het een top product. De afdruk is geweldig geworden.
Tags
Andere Info
Product ID: 175458606183141565
Ontworpen op: 26-7-2016 11:38
Rating: G
Recent bekeken items